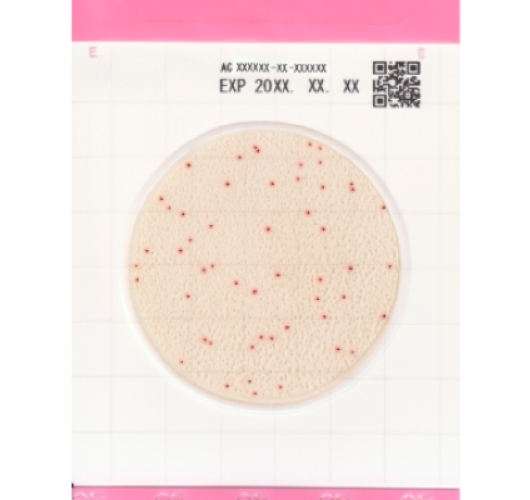
Аэробные бактерии - Easy Plate AC
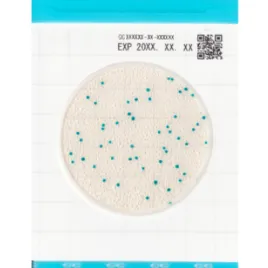
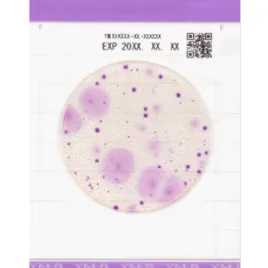

Аэробные бактерии - Easy Plate AC
Цена 13500 ₽
ЗаказатьКатегория:
Microorganism: Аэробные бактерии
Производитель:
Артикул: 61973
Кол-во: 100 шт.
Easy Plate AC — это удобная пластина со средой для роста аэробных бактерий.
Рост колоний, благодаря красному цвету, позволяет легко идентифицировать и подсчитывать аэробные бактерии в течение 48±2 часов.
Не требующая подготовки или стерилизации.
Время инкубации: 24 ± 1 час
Температура инкубации: 35±1℃
Температура хранения: 2 - 8℃
Срок годности: 18 месяцев
Упаковка: 100 тестов (25 тестов х 4 пакета)